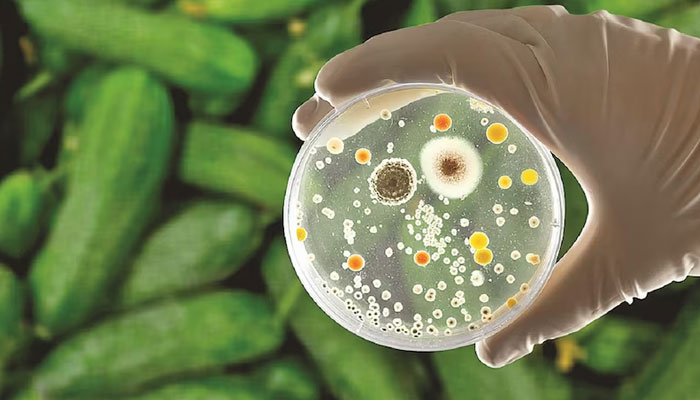
A representational image showing a petri dish. — Reuters/File

75 sickened as McDonald’s severe E. Coli outbreak expands in US
WASHINGTON: A severe outbreak of E. Coli linked to McDonald´s Quarter Pounder burgers has expanded to 75 reported cases, mainly in the western United States, authorities said on Friday.
The number of hospitalisations has risen to 22, though no additional deaths have been reported beyond that of an elderly patient in Colorado, according to the Food and Drug Administration (FDA) and the Centres for Disease Control and Prevention (CDC).
One child and one adult developed hemolytic uremic syndrome, a serious condition that damages blood vessels in the kidneys.
Investigators have yet to confirm a specific ingredient as the contamination source, though they are assessing whether slivered onions or beef patties could be the origin. While the investigation is underway, Taylor Farms, which supplies the slivered onions to affected locations, has issued a voluntary recall of its yellow onions.
McDonald´s restaurants in the 13 impacted states have temporarily pulled Quarter Pounders from their menus, though other items, including other beef burgers, remain available. Shares of the fast-food giant dropped more than two percent in early afternoon trading.
Meanwhile, the law firms Ron Simon & Associates and Meyers & Flowers have filed lawsuits on behalf of two separate consumers from Colorado and Nebraska who fell ill after consuming the burgers. Each suit seeks a minimum of $50,000 in damages, and attorney Ron Simon told AFP he plans to represent a total of 25 victims.
“And here, whether it was faulty testing, faulty oversight, faulty handling, somehow poison got in that food, and trust is broken.” The CDC advised those who consumed a Quarter Pounder and developed symptoms of E. coli poisoning -- such as diarrhea, bloody diarrhea, a fever over 102 degrees Fahrenheit (38.9°C), and vomiting -- to seek medical attention.
-
 South Korea: Two Killed As Military Helicopter Crashes During Training
South Korea: Two Killed As Military Helicopter Crashes During Training -
 Elon Musk Unveils SpaceX’s Moon-first Strategy With ‘self Growing Lunar City’
Elon Musk Unveils SpaceX’s Moon-first Strategy With ‘self Growing Lunar City’ -
 Donald Trump Slams Bad Bunny's Super Bowl Performance: 'Absolutely Terrible'
Donald Trump Slams Bad Bunny's Super Bowl Performance: 'Absolutely Terrible' -
 Jake Paul Criticizes Bad Bunny's Super Bowl LX Halftime Show: 'Fake American'
Jake Paul Criticizes Bad Bunny's Super Bowl LX Halftime Show: 'Fake American' -
 Prince William Wants Uncle Andrew In Front Of Police: What To Expect Of Future King
Prince William Wants Uncle Andrew In Front Of Police: What To Expect Of Future King -
 Antioxidants Found To Be Protective Agents Against Cognitive Decline
Antioxidants Found To Be Protective Agents Against Cognitive Decline -
 Hong Kong Court Sentences Media Tycoon Jimmy Lai To 20-years: Full List Of Charges Explained
Hong Kong Court Sentences Media Tycoon Jimmy Lai To 20-years: Full List Of Charges Explained -
 Coffee Reduces Cancer Risk, Research Suggests
Coffee Reduces Cancer Risk, Research Suggests -
 Katie Price Defends Marriage To Lee Andrews After Receiving Multiple Warnings
Katie Price Defends Marriage To Lee Andrews After Receiving Multiple Warnings -
 Seahawks Super Bowl Victory Parade 2026: Schedule, Route & Seattle Celebration Plans
Seahawks Super Bowl Victory Parade 2026: Schedule, Route & Seattle Celebration Plans -
 Keto Diet Emerges As Key To Alzheimer's Cure
Keto Diet Emerges As Key To Alzheimer's Cure -
 Chris Brown Reacts To Bad Bunny's Super Bowl LX Halftime Performance
Chris Brown Reacts To Bad Bunny's Super Bowl LX Halftime Performance -
 Trump Passes Verdict On Bad Bunny’s Super Bowl Halftime Show
Trump Passes Verdict On Bad Bunny’s Super Bowl Halftime Show -
 Super Bowl 2026 Live: Seahawks Defeat Patriots 29-13 To Win Super Bowl LX
Super Bowl 2026 Live: Seahawks Defeat Patriots 29-13 To Win Super Bowl LX -
 Kim Kardashian And Lewis Hamilton Make First Public Appearance As A Couple At Super Bowl 2026
Kim Kardashian And Lewis Hamilton Make First Public Appearance As A Couple At Super Bowl 2026 -
 Romeo And Cruz Beckham Subtly Roast Brooklyn With New Family Tattoos
Romeo And Cruz Beckham Subtly Roast Brooklyn With New Family Tattoos